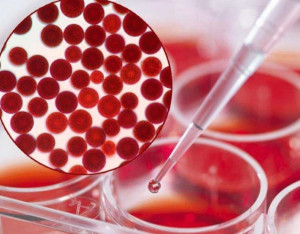

- 抗氧化

抗氧化
自由基
 抗氧化(4)人若要活着,除了要有食物供给充足的营养外,更需要靠不断地呼吸来获得氧气,氧气更是身体进行各种氧化反应所必需的,然而当人体正在利用氧气进行某些代谢反应时,不可避免地会产生一些不稳定物质,而这些不稳定的物质都是氧气的“变身”,它们的个性非常活泼,不喜欢安安稳稳地呆在原地,甚至喜欢去攻击别人,由于它们这种不喜欢受拘束的个性,称之为自由基。
抗氧化(4)人若要活着,除了要有食物供给充足的营养外,更需要靠不断地呼吸来获得氧气,氧气更是身体进行各种氧化反应所必需的,然而当人体正在利用氧气进行某些代谢反应时,不可避免地会产生一些不稳定物质,而这些不稳定的物质都是氧气的“变身”,它们的个性非常活泼,不喜欢安安稳稳地呆在原地,甚至喜欢去攻击别人,由于它们这种不喜欢受拘束的个性,称之为自由基。
自由基这种不受束缚的个性固然令人头痛,但有时人体反而需要藉由自由基的活性来消灭某些侵入人体的微生物或不正常细胞。因此,活泼的自由基也有它们可爱的一面。当人体内自由基的浓度不是很高时,身体自有一套完善的系统来消灭这些自由基,该系统称为抗氧化系统:可是,很不幸的,生活的空间及形态均会造成体内自由基浓度大大增加,如吸烟、空气污染、水污染、放射线(x 线,紫外线),杀虫剂、生活压力大、运动过度等,以上这些会使自由基浓度增加的情形,称之为氧化压力。氧化压力越大,体内自由基的浓度就越高,此时,身体中的抗氧化系统将面临不够使用的危机。
概括来讲,自由基的来源有以下几方面:
1. 抽烟 ( 二手烟 )、酗酒 ( 每根烟会产生 10,000,000,000,000,000 个自由基 )。
2. 辐射、紫外线、电磁波、日光曝晒,或癌症患者接受的放射线治疗,都会产生自由基。
3. 环境污染,包括空气污染、饮用水污染、工业废水污染、土壤污染等。
4. 化学药物滥用,如食品添加剂、农药、蔬果污染、毒品、治病药物等的滥用 ( 特别是没有经过试药的验方 )。
5. 精神状况,压力过大、急躁、焦虑、郁闷、紧张等情绪问题,也会产生自由基。
6. 现代都市人,生活压力大,居住环境不佳,充满各种污染,体内自由基泛滥,如果不加以控制,每天可能会遭受数十亿个自由基无情的攻击。
重要性
 抗氧化的水果越来越多的研究显示抗氧化是预防衰老的重要步骤,因为自由基或氧化剂会将细胞和组织分解,影响代谢功能,并会引起不同的健康问题。如果能够消除过多的氧化自由基,对于许多自由基引起的及老化相关疾病都能够预防。例如常见的癌症、动脉硬化、糖尿病、白内障、心血管病、老年痴呆、关节炎等,这些疾病都被认为与自由基相关。
抗氧化的水果越来越多的研究显示抗氧化是预防衰老的重要步骤,因为自由基或氧化剂会将细胞和组织分解,影响代谢功能,并会引起不同的健康问题。如果能够消除过多的氧化自由基,对于许多自由基引起的及老化相关疾病都能够预防。例如常见的癌症、动脉硬化、糖尿病、白内障、心血管病、老年痴呆、关节炎等,这些疾病都被认为与自由基相关。
应摄取足够的抗氧化剂,延缓身体退化速度,防止肌肤衰老,并时刻保持青春神采。抗氧化剂能在自然饮食中找到,是被称为三大抗氧化物质的维生素C、维生素E、和β-胡萝卜素。自然界中被称为抗氧化之王的虾青素其抗氧化能力是维生素C的6000倍,是维生素E的1000倍,是β-胡萝卜素功效的100倍;他们可以利用自身结构的特性来稳定自由基多余的电子,防止对细胞造成老化。但在繁忙的都市里,亦可选择天然营养补充品来摄取足够的抗氧化剂。
山竹、绿茶、红萝卜、石榴等有增强身体抗氧化防卫系统、保护细胞免受自由基侵害、促进新陈代谢的作用。
抗氧化物质
(1)天然虾青素:是一种强力的抗氧化剂,被称为抗衰老之王,其清除自由基的能力:是维生素C的功效的6000倍;是维生素E的1000倍;是β-胡萝卜素功效的100倍;是硒功效的20倍;是花青素功效的700倍;是茶多酚功效的320倍;是番茄红素功效的10倍;是辅酶Q10的800倍;:是葡萄籽提取物功效的240倍;是carotol(叶黄素)功效的200倍;是白藜芦醇的3000倍。[2]
(2)维生素C:又称抗坏血酸,是一种含有6个碳原子的酸性多羟基化合物:缺乏可大大降低耐力运动能力。补充维生素C可明显降低运动诱导的氧化应激。补充维生素C的安全剂量是0.5~3.0克/天。推荐每天补充维生素C的剂量为0.5~2.0克。
 抗氧化物质(3)维生素E:维生素E是细胞膜内重要的抗氧化物和膜稳定剂。维生素E在维持肌肉组织的正常机构和代谢,特别是在肌肉收缩期间的能量供给和钙离子摄取和释放有着重要的作用。补充维生素 E(400~1,600国际单位/天)可减少由大强度运动或其它情况引起自由基增加对机体的损伤。在高于海平面时,补充维生素 E可防止运动能力的降低。因此,认为在高于海平面训练的运动员补充维生素 E有利于运动成绩的提高。推荐每天补充(d-α-生育酚)维生素E的剂量为: 400~800国际单位。
抗氧化物质(3)维生素E:维生素E是细胞膜内重要的抗氧化物和膜稳定剂。维生素E在维持肌肉组织的正常机构和代谢,特别是在肌肉收缩期间的能量供给和钙离子摄取和释放有着重要的作用。补充维生素 E(400~1,600国际单位/天)可减少由大强度运动或其它情况引起自由基增加对机体的损伤。在高于海平面时,补充维生素 E可防止运动能力的降低。因此,认为在高于海平面训练的运动员补充维生素 E有利于运动成绩的提高。推荐每天补充(d-α-生育酚)维生素E的剂量为: 400~800国际单位。
(4)胡萝卜素类:β-胡萝卜素是维生素A的前体,具有清除自由基的功能,所以β-胡萝卜素对运动时的氧化应激有保护作用。推荐的β-胡萝卜素补充量是每天25,000-100,000国际单位。
(5)植物活性硒:硒是机体抗氧化系统组成成分谷胱甘肽过氧化物酶的必需成分,适当补硒可提高谷胱甘肽过氧化物酶活力,从而提高机体的抗氧化能力。有人报道给游泳运动员每天补充硒100~150微克可减少体内脂质过氧化,提示补硒对耐力运动员可能有益。建议的补硒剂量为每天100~250微克。
(6)花青素:花青素属于生物类黄酮物质,而黄酮物质最主要的生理活性功能是自由基清除能力和抗氧化能力。
(7)茶多酚:茶多酚是从茶叶中提取的全天然抗氧化食品,具有抗氧化能力强,无毒副作用,无异味等特点。茶叶多酚类的抗氧化作用因为能够消除活性氧,进而抑制维生素C的消耗,所以可以保持肌肤细致美白。
 抗氧化物质
抗氧化物质
(8)辅酶Q10:辅酶Q是机体中要使用氧的所有细胞的必需成分,因为它是物质氧化产生能量的过程中的氧化磷酸化呼吸链的电子传递体,运动中能量的需求大大增加,所以辅酶Q10可减少人心脏和肌肉自由基生成。对于要维持身体健康的人来说,辅酶Q的推荐使用量为每天30毫克,如果用治疗各种疾病,所使用的量就要高于这一剂量。
(9)葡萄籽提取物:葡萄籽提取物具有一定抗氧化作用,也能抗凝。所以,美国国家补充和综合健康中心建议,血液病患者、服用抗凝药患者以及即将手术者不应服用葡萄籽提取物。[3]
(10)叶黄素。开心果翠绿色的果仁中含有较丰富的叶黄素。叶黄素也具有较强的抗氧化作用。此外,叶黄素还能对抗视网膜黄斑病变。[4]
(11)白藜芦醇。白藜芦醇也是著名的天然抗氧化剂之一,可清除自由基,抑制脂质过氧化反应。除保护心血管系统之外,白藜芦醇还具有提高免疫力、抗癌、抗病毒、抗衰老等多种功效。[4]
护肤品
虾青素抗氧化化妆品成分解析:
虾青素抗氧化化妆品成分解析:
生育酚乙酸酯:是维生素E的衍生物,在化妆品中常做抗氧化剂使用,效果好又极其安全,因此使用非常广泛。
葡萄多酚:葡萄梗、籽、皮中多种成分组合起来的复合分子。除了葡萄中含有大量的葡萄多酚外,小蓝莓、欧洲越莓、樱桃、红茶、绿茶、柠檬、大麦外壳中也存在这种成分,只不过葡萄中的含量最高,葡萄籽的含量在葡萄中又居首位。葡萄多酚的作用主要原理就是对抗自由基,它可以和自由基相结合,使自由基失去攻击体内细胞的能力。
辅酵素Q10:在人体中有抗氧化的功能,可以消灭自由基,维持细胞膜的完整和稳定。单独服用辅酵素Q10或与维他命E一起服用, 会产生很强力的抗氧化剂。另外,它在强化身体制造能量的过程中扮演很重要的角色,它能够强化心脏机能,缓解缺氧状况。保健品中也经常使用。
虾青素:又叫虾红素,是一种类胡萝卜素。在自然界中,虾青素是由藻类、细菌和浮游植物产生的。某些鱼类和虾类以及螃蟹什么的通过吃这些藻类和浮游生物,就会把这种色素储存在壳中,所以他们表面就会呈现青色。
虾青素有着非常好的抗氧化能力,是维生素C的功效的6000倍;是维生素E的1000倍;是β-胡萝卜素功效的100倍;是花青素功效的700倍;是茶多酚功效的320倍;是番茄红素功效的10倍;是辅酶Q10的800倍;是红酒多酚的240倍;是carotol(叶黄素)功效的200倍;
食物
山竹
山竹又称莽吉柿、风果、倒稔子,属藤黄科藤黄属,有热带“果后”之美称。在东南亚,山竹果皮一直作为泰国传统医药,用于腹痛、腹泻、痢疾、感染性创伤、化脓、慢性溃疡、淋病、白血病和败血病等疾病的治疗,还具有明显的抗过敏和平喘活性。
氧杂蒽酮 (xanthones)是山竹药效和保健的主要活性物质,在山竹果皮、果壳中含量丰富。研究人员已经在山竹果皮中鉴定和分离了约40种氧杂蒽酮,如α-倒捻子素 、β-倒捻子素、γ-倒捻子素等。这些氧杂蒽酮普遍拥有抗惊厥、抗突变、抗炎、抗肿瘤、抗氧化及利尿活性,被用来帮助减轻胃肠紊乱、皮肤紊乱、炎症、传染病症状和降低胆固醇水平。
氧杂蒽酮的抗氧化特性也表现在其对癌症的化学预防上。研究中表明,天然α-倒捻子素被 7,12-二甲基苯(α-)蒽诱导后能够抑制试验鼠乳腺器官的早期病变;天然α-倒捻子素在短期结肠癌的生物鉴定中表现出极强的化学预防效果;6种从山竹果皮中分离到的氧杂蒽酮能抑制人白血病细胞 HL60,其中10μmol的α-倒捻子酮通过诱导程序细胞死亡,对HL60显示出完全抑制作用。
番茄
 番茄番茄中含有丰富的茄红素,茄红素具有抗氧化功能。
番茄番茄中含有丰富的茄红素,茄红素具有抗氧化功能。
另外,番茄应怎样食用才能对抗氧化更有效呢?那便是熟吃。虽然经烹调或加工过的番茄(番茄酱、番茄汁、罐装番茄)所含的维生素C会遭到破坏,但是茄红素的含量可增加数倍,抗氧化功能也更超强。
葡萄
葡萄籽中的花青配糖体,其抗氧化能力是维生素C的20倍、维生素E的50倍。用葡萄酿成的红酒因经过发酵,其抗氧化能力得以提高。因此,在吃葡萄的同时,再适量饮用些红酒,可以达到抗氧化的目的。
鲑鱼
 鲑鱼味美好吃的鲑鱼中,因含有超强的omega-3多元不饱和脂肪酸,所以有强的抗氧化功效,当然,野生鲑鱼的火力绝对比养殖的鲑鱼更超强。
鲑鱼味美好吃的鲑鱼中,因含有超强的omega-3多元不饱和脂肪酸,所以有强的抗氧化功效,当然,野生鲑鱼的火力绝对比养殖的鲑鱼更超强。
坚果
富含维生素E的坚果类食物(腰果、核桃、榛子、花生等)除了具有抗氧化功能之外,还能修护皮肤组织,不过,又因为坚果类食物含有高油脂,如果摄取过量,不但有致胖的危险,由高油脂所造成的氧化反应还会损害维生素E的抗氧化作用。因此,营养师建议人们要摄取此类食物,但又要适量,否则过犹不及。[5]
花椰菜
除了含有丰富的维生素A、C之外,它还含有一种特有的抗氧化物质,几乎集所有抗氧化物于一身,因此,它的抗氧化性能比其他食物更优良,而且还是抗癌明星。
蓝莓
 燕麦莓类水果富含β—胡萝卜素以及维生素C,而这两种成分是抗氧化物里最为医学界所肯定的物质,所以外形小巧、美观的草莓、蓝莓、小红莓你要大啖特啖。另外它所含有的钾及水溶性纤维,还能降低血胆固醇浓度及减少患高血压的几率。
燕麦莓类水果富含β—胡萝卜素以及维生素C,而这两种成分是抗氧化物里最为医学界所肯定的物质,所以外形小巧、美观的草莓、蓝莓、小红莓你要大啖特啖。另外它所含有的钾及水溶性纤维,还能降低血胆固醇浓度及减少患高血压的几率。
大蒜
别因为害怕大蒜的味道而远离大蒜,它不但具有抗氧化的功效,还有促进血液循环、加速新陈代谢的功能,能帮助排毒减重呢!它所含有的硫化物具有抗氧化还原作用,不但可有效降低体内胆固醇,还可预防高血压及心血管疾病。如果你实在对大蒜没感情,不妨吃些蒜苗、蒜叶、蒜油。还要记住,如果吃过大蒜之后喝杯牛奶,恼人的蒜味在半个小时内便没了,不信你可试试。[6]
菠菜
菠菜因富含β—胡萝卜素和维生素C,所以也上了抗氧化食物十佳排行榜。菠菜中的大量抗氧化剂,既能激活大脑功能,又可增强青春活力,有助于防止大脑的老化,防治老年痴呆。
燕麦
富含蛋白质、钙、核黄素、硫胺素等成分的燕麦是五谷杂粮中惟一荣登十佳抗氧化食物排行榜的。每日摄取适量的燕麦能加速人体新陈代谢,加速氨基酸的合成,促进细胞更新。
绿茶
 绿茶绿茶中含有茶多酚。多酚类的抗氧化作用因为能够消除活性氧,进而抑制维生素C的消耗,所以可以清除体内自由基。同时还具有去油解腻、清新口气的功能。
绿茶绿茶中含有茶多酚。多酚类的抗氧化作用因为能够消除活性氧,进而抑制维生素C的消耗,所以可以清除体内自由基。同时还具有去油解腻、清新口气的功能。
海藻
营养专家帕特里克·霍尔福德说:“海藻和绿色的蔬菜富含叶绿素,叶绿素可以起到增强血液中血红细胞生成的作用。”另外海藻中还富含各种酶、矿物质、维生素,不仅极具抗氧化性而且还具有清除人体垃圾的功能。
柚子
霍尔福德说:“柚子中富含的生物类黄酮是一种强大的抗氧化成分,其可以与有毒的金属物质捆绑在一起并将这些毒物赶出体外。另外,生物类黄酮还有助于使得维生素C在人体组织中更为稳定,这有助于起到抗炎症和抗癌的作用。”生物类黄酮在水果中的含量较高,同时也有助于人体吸收。
黑枸杞
黑枸杞最突出的成分为花青素,花青素是一种强效的抗氧化剂;可防止过早衰老,增强血管弹性,抑制过敏及炎症,改善关节柔韧性。
山楂
所含有的黄酮类物质和维生素C、胡萝卜素等能阻断并减少自由基的生成,增强机体的免疫力,还有防衰老、抗癌的作用。
红葡萄酒
葡萄中含的原花青素和白黎芦醇都是强力抗氧化剂,可抗衰老,并可清除体内的自由基。吃葡萄应尽量连皮和籽一起吃,因为葡萄的很多营养成分都存在于皮和籽中。
胡萝卜
 胡萝卜胡萝卜不仅能够增强人体免疫力,有抗癌作用,它更含有丰富的胡萝卜素,胡萝卜素可以清除致人衰老的单线态氧和自由基,减缓人体衰老的过程,防止皮肤老化[7]。
胡萝卜胡萝卜不仅能够增强人体免疫力,有抗癌作用,它更含有丰富的胡萝卜素,胡萝卜素可以清除致人衰老的单线态氧和自由基,减缓人体衰老的过程,防止皮肤老化[7]。
黄豆
含有异黄酮,是一种天然抗氧化剂,同时具有弱雌性激素作用。常喝豆浆可以明显减弱妇女更年期症状,而且还有防癌和预防老年痴呆症的作用。对女性有很好的美容养颜的功效。
天然成熟蜂蜜
 天然成熟蜂蜜忙碌一天之后,印度人通常爱坐下来喝一杯暖暖的生姜茶。做法很简单,在开水中加入生姜片,待茶水温度适宜时加天然成熟蜂蜜饮用:姜茶有多种抗衰老功效。天然成熟蜂蜜具有自然抗菌属性,有助于减少皮肤炎症;生姜富含抗氧化剂姜酮醇(也称姜酚或姜辣素),该物质可防止胶原质分解,因而有助于保持皮肤滋润饱满。
天然成熟蜂蜜忙碌一天之后,印度人通常爱坐下来喝一杯暖暖的生姜茶。做法很简单,在开水中加入生姜片,待茶水温度适宜时加天然成熟蜂蜜饮用:姜茶有多种抗衰老功效。天然成熟蜂蜜具有自然抗菌属性,有助于减少皮肤炎症;生姜富含抗氧化剂姜酮醇(也称姜酚或姜辣素),该物质可防止胶原质分解,因而有助于保持皮肤滋润饱满。
可以每天早晚各一次天然成熟蜂蜜,深色天然成熟蜂蜜含有不同浓度的多酚物质(polyphenols-较强的抗氧化剂),这些成分是抗氧化剂,被认为可降低心脏病与癌症的发生几率。
美国戴维斯加州大学进行的研究结果显示,天然成熟蜂蜜是一种健康食品,含有数量惊人的抗氧化剂,他能清除体内的垃圾------氧自由基,有助于提高人体内有益健康的抗氧化剂水平,达到清除体内自由基的产生,有抗癌,防衰老的作用。天然成熟蜂蜜能促进皮肤红润细腻有光泽,戴维斯加州大学研究员海德龙·格罗辛博士日前在美国化学学会于加利福尼亚州举行的会议上,公布了她和同事们进行的这项研究结果。她说,在对25名志愿者参加的一项研究中,他们发现天然成熟蜂蜜能够提高人体内的抗氧化剂水平。[8]
樱桃
自古以来就是美容果。樱桃汁能帮助面部皮肤嫩白红润、去皱清斑,是不少美白产品的最爱。樱桃不仅富含维生素c,而且含铁极其丰富,是山楂的13倍,苹果的20倍。除了含铁量高之外,它还含有平衡皮质分泌、延缓老化的维生素a,帮助活化细胞、美化肌肤。
石榴
娇艳欲滴的红石榴已经被证实具有很强的抗氧化作用。它含有一种叫鞣花酸的成分,可以使细胞免于环境中的污染、uv射线的危害,滋养细胞,减缓肌体的衰老。有研究表明,鞣花酸在防辐射方面比红酒和绿茶中含有的多酚更“厉害”。
黄瓜
它的味道鲜美,脆嫩清香,备受瘦身人士的推崇。而且它富含人体生长发育和生命活动所必需的多种糖类和氨基酸,以及丰富的维生素,为皮肤、肌肉提供充足的养分,可有效地对抗皮肤老化,减少皱纹的产生。所含丰富的果酸,能清洁美白肌肤,消除晒伤和雀斑,缓解皮肤过敏。
柠檬
柠檬中含有维生素b1、维生素b2、维生素c等多种营养成分。此外,还含有丰富的有机酸,具有很强的抗氧化作用,对促进肌肤的新陈代谢、延缓衰老及抑制色素沉着等都十分有效。
评价方法
ORAC
ORAC是Oxygen Radical Absorption Capacity(氧化自由基吸收能力)的缩写,是一种测试抗氧化能力的评价方法体系。[5]
既然科学已证明抗氧化对人体的重要性,那么对抗
氧化效果进行量化是一个迫切需要解决的问题。只有抗氧化效果可以被量化,才能使企业研发出更好的产品、获得政府的认可、向消费者证明其产品抗氧化的有效性。
在ORAC方法未推出之前,因为抗氧化测试的极其复杂性,商业界(极其复杂的实验方案不可能被商业界所应用,当时一个严谨的抗氧化实验往往需要几个月,且费用巨贵,是商业界无法接受的)无法有效、全面的测试出样品的抗氧化力,然而商业是科技创新的动力,就像苹果公司。
ORAC抗氧化测试包括对:过氧化自由基(含亲水性、亲脂性)、羟基自由基、过氧亚硝基、单线态氧、超氧阴离子 这五种人体最主要的活性氧自由基进行全面的分析,能有效得出样品的抗氧化实际能力及分布情况。
ORAC抗氧化生物测试是比普通抗氧化测试的更高一层的测试方案。利用人体细胞有效测试出样品的抗氧化力(生物利用度)。
ORAC已被美国AOAC评定为抗氧化测试标准方法,是国际主流测试方法。
其他评价方法
抗氧化不仅仅是一个概念,对生物体抗氧化的效果是可以量化测定的,作为动物实验一般是服用抗氧化剂一定时间后,测定血液中的酯质过氧化产物丙二醛变化、以及肝脏匀浆中超氧化物歧化酶SOD和谷胱甘肽过氧化物酶GSH-PX的活力变化。从上述两种酶和MDA的变化状况来判定抗氧化的强度及效果。作为人体不可能测肝脏匀浆,可以测定血液或者尿液中的MDA,以及血液中的SOD、GXH-PX来判定抗氧化的效果。
食物中氧化剂长期以来倍受国内外学者关注,这是因为:
① 食物中抗氧化剂能够保护食物免受氧化损伤而变质。
② 在人体消化道内具有抗氧化作用,防止消化道发生氧化损伤。
③ 吸收后可在机体其他组织器官内发挥作用。
④ 来源于食物的某些具有抗氧化作用的提取物可以作为治疗药品。抗氧化剂的作用机理包括鳌合金属离子、清除自由基、淬灭单线态氧、清除氧、抑制氧化酶活性等。
体外评价方法
虽然很多,但主要基于两类一个是通过测定样品抑制脂类物质氧化的能力来评定被测物的抗氧化能力另一个是用样品对人工合成的自由基的清除能力来反映待测物的抗氧化活性。抗氧化剂在食品和生物体系中的抗氧化活性受很多因素的影响,其中主要包括抗氧化剂在水相和油相间的分配效应,氧化条件和环境,被氧化底物物理状态等。
1.抗油脂过氧化力测定
脂类包括的范围很广,是构成生物膜的主要成分,脂类中的不饱和脂肪酸可以过氧化,脂类过氧化过程中会产生L、LO、LOO-等自由基以及LOOH,这些产物会损伤生物细胞。因此,能够抑制脂类过氧化具有重要的生物学意义。
A硫氰酸铁法FTC:硫氰酸铁盐(FTC)比色法是基于在酸性条件下,脂质氧化形成的过氧化物可将Fe2+氧化成Fe3+,然后Fe3+与硫氰酸根离子可形成在480-515nm内有最大吸收的红色络合物。通常用500nm处吸光值的高低表示物质抗脂质过氧化的能力,吸光值越小,表明物质的抗脂质过氧化能力越强。
B硫代巴比妥酸反应物TBARs法:是评价油脂的氧化程度的常用方法。油脂或者亚油酸氧化后的终产物主要是丙二醛,这些过氧化产物与硫代巴比妥酸作用生成有色化合物,该有色化合物在530 nm左右有吸收。
2.清除DPPH能力的侧定
DP是一种早期合成的有机自由基,常用来评估抗氧化物的供氢能力,它在有机溶剂中非常稳定,呈紫色,而且在处有一个特征吸收峰,当遇到自由基清除剂时,DPPH的孤对电子被配对而使其退色,也就是在最大吸收波长处的吸光值变小。因此,可通过测定吸光值的变化来评价样品对DPPH自由基的清除效果。
3.还原能力的测定
还原力的测定是检验样品是否是良好的电子供体的方法,还原力强的样品应该是良好的电子供应者,它供应的电子不仅能使Fe3+还原为Fe2+,也可以与自由基反应。还原力的测定是用来评价抗氧化剂活性的常用方法。
4.抑制 LOX酶实验
脂肪氧化酶LOX在植物中分布广泛是一种非血红素铁蛋白,分子量为90一100KD。这种酶蛋白有多个多肤链组成,含有三价铁离子金属辅基则有活性,而包含二价铁离子的金属辅基则缺乏活性。在生物体内的主要作用是,专一催化含有顺,顺一戊二烯结构的多元不饱和脂肪酸的加氧反应,生成具有共扼双键的多元不饱和脂肪酸的氢过氧化物。在生物体内的主耍底物是甘油脂类〔如磷脂)释放的游离不饱和脂肪酸,其中动物体内的主要底物是花生四烯酸,植物体内的主要底物是亚油酸和亚麻酸,主要产物为过氧羚基型脂肪酸。
上述方法是抗氧化剂的应用效果的体内、外测定评价方法。

-
氧化锌避雷器带电测试仪
2025-10-02 14:49:00 查看详情 -
氧化锌避雷器特性测试仪
2025-10-02 14:49:00 查看详情 -
二氧化碳气体保护焊机
2025-10-02 14:49:00 查看详情 -
汽车二氧化锆式氧传感器
2025-10-02 14:49:00 查看详情


 求购
求购






